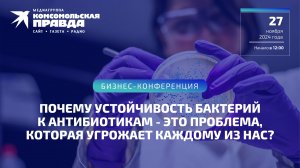
Почему устойчивость бактерий к антибиотикам - это проблема, которая угрожает каждому из нас?

37:27
37:27
2024-11-17 06:24

 1:23:34
1:23:34

 1:23:34
1:23:34
2024-11-17 04:53

 12:57
12:57

 12:57
12:57
2024-12-05 13:08

 19:39
19:39

 19:39
19:39
Тупиковая Ситуация и Мирные Переговоры: Россия Будет Диктовать Условия - Рэй МакГоверн | Стивен Гард
2023-11-23 18:29

 1:23:24
1:23:24
1:23:24
1:23:24
2024-11-27 11:59

 1:52:59
1:52:59

 1:52:59
1:52:59
2024-12-06 14:46

 34:16
34:16

 34:16
34:16
2024-12-02 16:59

 51:03
51:03

 51:03
51:03
2024-11-19 17:01
![Ковер Майское чудо. Часть 1. Вяжем вместе!_[360p].mp4](https://pic.rutubelist.ru/video/cd/c2/cdc26ca85971bba7b00722139421bdce.jpg?width=300)
 59:29
59:29
![Ковер Майское чудо. Часть 1. Вяжем вместе!_[360p].mp4](https://pic.rutubelist.ru/video/cd/c2/cdc26ca85971bba7b00722139421bdce.jpg?width=300)
 59:29
59:29
2022-07-23 12:59

 43:04
43:04

 43:04
43:04
2024-11-25 16:13

 1:12:39
1:12:39

 1:12:39
1:12:39
2025-11-26 19:00

 1:30:00
1:30:00

 1:30:00
1:30:00
2025-11-26 16:00

 55:58
55:58

 55:58
55:58
2025-11-27 20:22

 1:55:17
1:55:17

 1:55:17
1:55:17
2025-10-25 21:00

 50:45
50:45

 50:45
50:45
2025-11-27 19:00

 46:30
46:30
![Ольга Стельмах – Не будем всё усложнять (Премьера клипа 2025)]() 4:01
4:01
![Аброр Киличов - Тим-Тим (Премьера клипа 2025)]() 4:42
4:42
![Ислам Айдаров - Певица в ресторане (Премьера клипа 2025)]() 2:57
2:57
![Ислам Итляшев - Не реви (Премьера клипа 2025)]() 2:41
2:41
![АКУЛИЧ - Красные глаза (Премьера клипа 2025)]() 2:13
2:13
![Алмас Багратиони - Дети света (Премьера клипа 2025)]() 2:52
2:52
![Искандар Шокалонов - Севгани бор уни Онажон (Премьера клипа 2025)]() 3:05
3:05
![SHAXO - Пьяница (Премьера клипа 2025)]() 3:32
3:32
![Камилла - Не плачь, девчонка (Премьера клипа 2025)]() 3:10
3:10
![Тахмина Умалатова - Растворяюсь (Премьера клипа 2025)]() 3:22
3:22
![Азамат Исенгазин - Мой свет (Премьера 2025)]() 2:47
2:47
![Enrasta - Франция (Премьера клипа 2025)]() 2:44
2:44
![Илёс Юнусий - Сиз зурсиз Дада (Премьера клипа 2025)]() 3:55
3:55
![ZIMMA - Город Тает (Премьера клипа 2025)]() 2:30
2:30
![Леся Кир - Альфонс (Премьера клипа 2025)]() 3:23
3:23
![Евгений Коновалов - Чиста реченька (Премьера клипа 2025)]() 2:52
2:52
![Одилхужа Нодиров - Бегонадек (Премьера клипа 2025)]() 4:07
4:07
![POLAT - Лунная (Премьера клипа 2025)]() 2:34
2:34
![Наталья Влади - Математика (Премьера клипа 2025)]() 2:30
2:30
![Ozoda - Chamadon (Official Video 2025)]() 5:23
5:23
![Paзpушитeль миpoв | Worldbreaker (2025)]() 1:34:45
1:34:45
![Бешеные псы | Reservoir Dogs (1991) (Гоблин)]() 1:39:10
1:39:10
![Тот самый | Him (2025)]() 1:36:20
1:36:20
![Свайпнуть | Swiped (2025)]() 1:50:35
1:50:35
![Сны поездов | Train Dreams (2025)]() 1:43:45
1:43:45
![Большой Лебовски | The Big Lebowski (1998) (Гоблин)]() 1:56:59
1:56:59
![Семейный план 2 | The Family Plan 2 (2025)]() 1:46:14
1:46:14
![Стив | Steve (2025)]() 1:33:34
1:33:34
![Крысы: Ведьмачья история | The Rats: A Witcher Tale (2025)]() 1:23:01
1:23:01
![Терминатор 2: Судный день | Terminator 2: Judgment Day (1991) (Гоблин)]() 2:36:13
2:36:13
![Убойная суббота | Playdate (2025)]() 1:34:35
1:34:35
![Заклятие 4: Последний обряд | The Conjuring: Last Rites (2025)]() 2:15:54
2:15:54
![Орудия | Weapons (2025)]() 2:08:34
2:08:34
![Чумовая пятница 2 | Freakier Friday (2025)]() 1:50:38
1:50:38
![После охоты | After the Hunt (2025)]() 2:20:25
2:20:25
![Большой куш / Спи#дили | Snatch (2000) (Гоблин)]() 1:42:50
1:42:50
![Чёрный телефон 2 | Black Phone 2 (2025)]() 1:53:55
1:53:55
![Только ты | All of You (2025)]() 1:38:22
1:38:22
![Богомол | Samagwi (2025)]() 1:53:29
1:53:29
![Фантастическая четвёрка: Первые шаги | The Fantastic Four: First Steps (2025)]() 1:54:40
1:54:40
![Рэй и пожарный патруль Сезон 1]() 13:27
13:27
![Ну, погоди! Каникулы]() 7:09
7:09
![Последний книжный магазин]() 11:20
11:20
![Пип и Альба Сезон 1]() 11:02
11:02
![Забавные медвежата]() 13:00
13:00
![Команда Дино. Исследователи Сезон 2]() 13:26
13:26
![Сборники «Умка»]() 1:20:52
1:20:52
![Тёплая анимация | Новая авторская анимация Союзмультфильма]() 10:46
10:46
![МегаМен: Полный заряд Сезон 1]() 10:42
10:42
![Сборники «Приключения Пети и Волка»]() 1:50:38
1:50:38
![Мотофайтеры]() 13:10
13:10
![Пиратская школа]() 11:06
11:06
![Истории Баданаму Сезон 1]() 10:02
10:02
![Корги по имени Моко. Домашние животные]() 1:13
1:13
![Игрушечный полицейский Сезон 1]() 7:19
7:19
![Кадеты Баданаму Сезон 1]() 11:50
11:50
![Новое ПРОСТОКВАШИНО]() 6:30
6:30
![Псэмми. Пять детей и волшебство Сезон 1]() 12:17
12:17
![Оранжевая корова]() 6:30
6:30
![Агент 203]() 21:08
21:08

 46:30
46:30Скачать Видео с Рутуба / RuTube
| 256x144 | ||
| 424x240 | ||
| 640x360 | ||
| 856x480 | ||
| 1280x720 | ||
| 1920x1080 |
 4:01
4:01
2025-11-21 13:05
 4:42
4:42
2025-11-17 14:30
 2:57
2:57
2025-11-26 14:50
 2:41
2:41
2025-11-18 12:35
 2:13
2:13
2025-11-15 12:35
 2:52
2:52
2025-11-20 13:43
 3:05
3:05
2025-11-25 11:25
 3:32
3:32
2025-11-18 12:49
 3:10
3:10
2025-11-27 12:41
 3:22
3:22
2025-11-27 11:30
 2:47
2:47
2025-11-19 11:44
 2:44
2:44
2025-11-20 21:37
 3:55
3:55
2025-11-27 13:01
 2:30
2:30
2025-11-21 13:20
 3:23
3:23
2025-11-19 11:51
 2:52
2:52
2025-11-27 12:09
 4:07
4:07
2025-11-27 12:54
 2:34
2:34
2025-11-21 13:26
 2:30
2:30
2025-11-26 12:08
 5:23
5:23
2025-11-21 13:15
0/0
 1:34:45
1:34:45
2025-11-27 19:40
 1:39:10
1:39:10
2025-09-23 22:53
 1:36:20
1:36:20
2025-10-09 20:02
 1:50:35
1:50:35
2025-09-24 10:48
 1:43:45
1:43:45
2025-11-26 14:01
 1:56:59
1:56:59
2025-09-23 22:53
 1:46:14
1:46:14
2025-11-26 06:44
 1:33:34
1:33:34
2025-10-08 12:27
 1:23:01
1:23:01
2025-11-05 19:47
 2:36:13
2:36:13
2025-10-07 09:27
 1:34:35
1:34:35
2025-11-19 10:39
 2:15:54
2:15:54
2025-10-13 19:02
 2:08:34
2:08:34
2025-09-24 22:05
 1:50:38
1:50:38
2025-10-16 16:08
 2:20:25
2:20:25
2025-11-27 19:24
 1:42:50
1:42:50
2025-09-23 22:53
 1:53:55
1:53:55
2025-11-05 19:47
 1:38:22
1:38:22
2025-10-01 12:16
 1:53:29
1:53:29
2025-10-01 12:06
 1:54:40
1:54:40
2025-09-24 11:35
0/0
2021-09-22 23:51
 7:09
7:09
2025-08-19 17:20
 11:20
11:20
2025-09-12 10:05
2021-09-22 23:37
 13:00
13:00
2024-12-02 13:15
2021-09-22 22:54
 1:20:52
1:20:52
2025-09-19 17:54
 10:46
10:46
2022-06-07 11:02
2021-09-22 21:43
 1:50:38
1:50:38
2025-10-29 16:37
 13:10
13:10
2024-11-27 14:57
 11:06
11:06
2022-04-01 15:56
2021-09-22 21:29
 1:13
1:13
2024-11-29 14:40
2021-09-22 21:03
2021-09-22 21:17
 6:30
6:30
2018-04-03 10:35
2021-09-22 22:23
 6:30
6:30
2022-03-31 18:49
 21:08
21:08
2025-01-09 16:39
0/0

